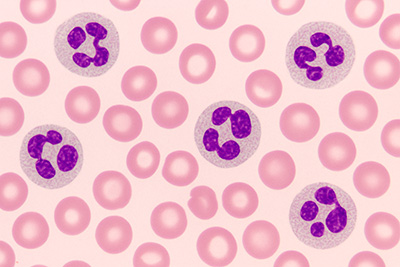

🔬 Aprende a identificar las alteraciones más comunes de la serie roja en laboratorio con seguridad clínica, sin dudas ni adivinanzas
👉 Domina el diagnóstico visual en minutos con esta guía práctica y actualizada

Basado en más de 15 años de experiencia clínica por hematólogos y bioanalistas 🥇
🔍 TE INCLUYE:
✅ +60 microfotografías reales de la serie roja,
imágenes diagnósticas en alta calidad y formato profesional.
✅ Cobertura total: anemias microcíticas, macrocíticas, hemolíticas, normocíticas, inclusiones eritrocitarias y casos mixtos diferenciales
✅ Cuadros clínicos completos con datos de paciente, hallazgos de laboratorio e interpretación diagnóstica
✅ Contenido clínico y visual, optimizado para móviles y tablets 📱💻
✅ Redactado con enfoque profesional por expertos en hematología de laboratorio
🧠 Útil para formación, repaso o actualización diagnóstica continua.
🔍 ¿Por qué este Bio Atlas es para ti?
✅ Acceso inmediato a imágenes reales y clasificadas de las células sanguíneas de la serie roja más relevantes.
✅ Mejora tus informes clínicos con evidencia visual confiable y bien fundamentada.
✅ Úsalo como una guía rápida de consulta diagnóstica en prácticas, estudios o laboratorios reales.
🎓 Diseñado para estudiantes, técnicos, bioanalistas y profesionales de la salud que requieren una guía visual clara y confiable en diagnóstico hematológico – Serie Roja.

📲 Tu herramienta clínica de bolsillo para dominar el diagnóstico hematológico de la serie roja.
🧠 ¿Qué aprenderás con este Bio Atlas?

🔬 Hematuria microscópica
🩸 Eritrocitos:
🩸 Isomórficos
🩸 Dismórficos
🩸 Sombras
🔍 Claves:
🔍 Levaduras
🔍 Lípidos
Piuria y leucocituria 🦠
🟢 Leucocitos:
🟢 Neutrófilos
🟢 Glitter cells
🟢 Linfocitos
🟢 Eosinófilos
📘 Cada hallazgo ilustrado con microfotografía auténtica, esquema comparativo y correlación clínica y de laboratorio.

Células epiteliales, inclusiones y cilindros 🧬
🧬 Epiteliales:
🧬 Escamosas
🧬 Transicionales
🧬 Tubulares renales
💎 Inclusiones:
💎 Cuerpos grasos
💎 Cristales
💎 Virales
🧫 Cilindros:
🧫 Eritrocitarios
🧫 Leucocitarios
🧫 Epiteliales
🧫 Grasos
🧫 Bacterianos

Microorganismos, artefactos y hallazgos poco frecuentes 🔍
🍄 Microorganismos:
🍄 Levaduras
🍄 Trichomonas
🍄 Hifas fúngicas
🍄 Parásitos raros
🔍 Artefactos:
🔍 Burbujas
🔍 Lípidos
🔍 Polen
⚠️ Especiales:
⚠️ Malignas
⚠️ Hongos
📘 Cada hallazgo acompañado de microfotografía real, cuadro comparativo y correlación clínico-laboratorial.
BENEFICIOS DE NUESTRO BIO ATLAS
🧠 Acceso de por vida
Pagas una sola vez y lo tienes para siempre. Sin mensualidades ni vencimientos
📲 Estudialo desde donde quieras
Compatible con celular, tablet o PC. Acceso inmediato y flexible
⚡ Entrega en segundos por correo electrónico
Recíbelo al instante una vez confirmado el pago. Sin esperas, sin envíos físicos
✅ Bio Atlas de Serie Roja
✅ Imágenes reales y en alta resolución
✅ Contenido actualizado y completo
✅ Lectura fluida desde cualquier dispositivo
❌ Otros atlas disponibles
❌ Imágenes borrosas o sacadas de internet
❌ Contenido básico y desactualizado
❌ Formato rígido y difícil de navegar
CONOCE LA EXPERIENCIA DE QUIENES YA DOMINAN EL DIAGNÓSTICO
👉 Así opinan profesionales, docentes y estudiantes que ya usan el Bio Atlas de Hematología Serie Roja
⭐⭐⭐⭐⭐




ESPERA...🎁
¡Bonos Exclusivos Incluidos por tu Acceso HOY!

🎁 BONO PREMIUM #1
20 Casos Clínicos de Hematología Serie Roja
Refuerza lo aprendido con 20 escenarios clínicos reales que simulan la práctica de laboratorio.
📌 Incluyen: datos de paciente, resultados, imágenes diagnósticas e interpretación paso a paso.
🚀 Practica como si estuvieras en el laboratorio, evita errores y afianza tu ojo clínico.
Valorado en 19 USD (GRATIS al inscribirte hoy)

🎁 BONO #2
Actualizaciones gratuitas para siempre
Recibirás todas las futuras actualizaciones del Bio Atlas, con nuevas imágenes, clasificaciones o descubrimientos clínicos, sin que tengas que volver a pagar ni un centavo.
📥 Siempre estarás al día con lo más reciente en parasitología.
Valorado en 17 USD (GRATIS al inscribirte hoy)

🎁 BONO #3
Descuentos Exclusivos y Acceso de por Vida
Por ser parte de BioAtlas Academy, recibirás descuento exclusivo y acceso vitalicio en futuros recursos como Bio Atlas de Citología, microbiología o urinálisis.
Valorado en 18 USD (GRATIS al inscribirte hoy)
¿Qué recibirás si accedes hoy?
🔬 Bio Atlas de Hematología Serie Roja
✅ (Actualizado 2025)
✅ Imágenes en ALTA CALIDAD
🎁 BONO PREMIUM #1 – 20 Casos clínicos
🎁 BONO #2 – Actualizaciones gratuitas
🎁 BONO #3 – Descuentos exclusivos y acceso de por vida
📩 Recíbelo directamente en tu correo electrónico
🧠 Mejora tu criterio clínico y evita errores que otros cometen
⏳ Postergar tu formación también retrasa tu crecimiento profesional
¡Domina hematología Serie Roja hoy mismo!

🛒 ÚNICO PAGO – SIN MENSUALIDADES
🌎 Paga en tu moneda local
✅ Domina lo que otros aún dudan
Las alteraciones hematológicas siguen siendo un reto clínico a nivel global, y conocerlas a fondo es clave para una formación profesional sólida.
Este Bio Atlas fue diseñado como una herramienta visual y práctica para facilitar el reconocimiento, estudio y diagnóstico de las principales patologías de la serie roja.
Dentro del atlas encontrarás una recopilación detallada de eritrocitos normales y patológicos, así como de las principales alteraciones morfológicas que reflejan enfermedades hematológicas de relevancia clínica.
Incluye microfotografías reales y descripciones claras que destacan los rasgos morfológicos clave de cada hallazgo, facilitando su identificación rápida y precisa en el laboratorio.
GARANTÍA DE SATISFACCIÓN

Estoy seguro de que este Bio Atlas será una herramienta valiosa en tu formación clínica.
Pero si por cualquier razón no cumple con tus expectativas, tienes 30 días para pedir el reembolso completo de tu dinero.
📩 Sin preguntas. Sin rodeos.
De esta forma, tu inversión está completamente protegida.

Nº1 en Educación Digital Científica 🥇📚
¿Cómo Funciona?
1. Haz clic en cualquier botón amarillo, llena con tus datos y realizas tu inscripción
2. Recibirás de inmediato los datos de acceso al Bio Atlas y a la plataforma de Hotmart en tu correo (Revisa bandeja de spam)
3. Elige una contraseña y accede al contenido al instante. ¡Disfrútalo!
4. Para acceder al Bio Atlas con facilidad descarga la aplicación de Hotmart en tus dispositivos inteligentes
PREGUNTAS FRECUENTES
Recibirás acceso inmediato en tu correo electrónico
Apenas completes tu inscripción, te llegará el Bio Atlas directamente a tu bandeja.
¡Nos vemos adentro y bienvenido a BioAtlas Academy! 🔬📘
El acceso es de por vida. Una vez que te registres, puedes ver el Bio Atlas cuando desees y las veces que quieras desde tu teléfono móvil, computadora, Tablet o TV.
No. Solo pagas una vez y tienes acceso al contenido por el resto de tu vida con actualizaciones constantes.
El Bio Atlas es 100% digital (formato PDF), así puedes acceder al instante, sin esperas ni envíos.
No. El Bio Atlas está diseñado para estudiantes y técnicos en formación. Todo está explicado de forma clara, con imágenes reales y texto fácil de seguir.
En caso de que no te llegue el correo de acceso, escribenos y te lo reenviamos manualmente.
Siempre vas a recibir lo que compraste. Garantizado.
🔬 Conviértete en quien domina el diagnóstico hematológico de la Serie Roja desde hoy
🧠 ¡No dejes tu formación clínica para después!
📚 Tu seguridad diagnóstica comienza con decisiones como esta
✅ Guía clara y actualizada
✅ Ideal para estudiantes, técnicos y profesionales del laboratorio
🌎 Paga en tu moneda local


DESCARGO DE RESPONSABILIDAD: Este sitio no forma parte de Facebook ni está respaldado por Facebook Inc. en ninguna forma. FACEBOOK es una marca registrada de Meta Platforms, Inc.